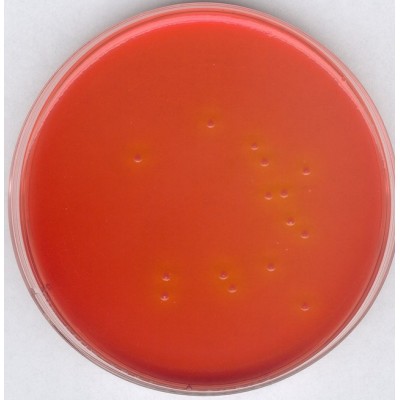
Los Angeles

SALMONELLA SHIGELLA AGAR (SS AGAR) GRANULADO REND. 60,0g/l GranuCult® MERCK 500 GR
Modelo: 1038530500
-
R$608,89
ou até 3x de R$202,96 sem juros
Economize 5% no PIX: R$578,45
ou 3.5% no boleto: R$587,58
Consulte aqui o valor do frete e prazo de entrega
Descrição
SALMONELLA SHIGELLA AGAR (SS AGAR) GRANULADO MERCK
RENDIMENTO 60,0g/l MS 80141300389
EMBALAGEM 500G
The medium complies with the recommendations of the APHA for the examination of food (1992).
Typical Composition (g/litre)
Peptones 10.0;
lactose 10.0;
ox bile 8.5;
sodium citrate 10.0;
sodium thiosulfate 8.5;
ammonium iron(III) citrate 1.0;
brilliant green 0.0003;
neutral red 0.025;
agar-agar 12.0.
Preparation and Storage
Usable up to the expiry date when stored dry and tightly closed at +15 to +25° C. Protect from light. After first opening of the bottle the content can be used up to the expiry date when stored dry and tightly closed at +15 to +25°C. Suspend 60 g/litre completely, pour plates.
Do not autoclave.
pH: 7.0 ± 0.2 at 25 °C.
The plates are clear and reddish-brown.
RENDIMENTO 60,0g/l MS 80141300389
EMBALAGEM 500G
The medium complies with the recommendations of the APHA for the examination of food (1992).
Typical Composition (g/litre)
Peptones 10.0;
lactose 10.0;
ox bile 8.5;
sodium citrate 10.0;
sodium thiosulfate 8.5;
ammonium iron(III) citrate 1.0;
brilliant green 0.0003;
neutral red 0.025;
agar-agar 12.0.
Preparation and Storage
Usable up to the expiry date when stored dry and tightly closed at +15 to +25° C. Protect from light. After first opening of the bottle the content can be used up to the expiry date when stored dry and tightly closed at +15 to +25°C. Suspend 60 g/litre completely, pour plates.
Do not autoclave.
pH: 7.0 ± 0.2 at 25 °C.
The plates are clear and reddish-brown.
Etiquetas: salmonella, shigella, agar ss